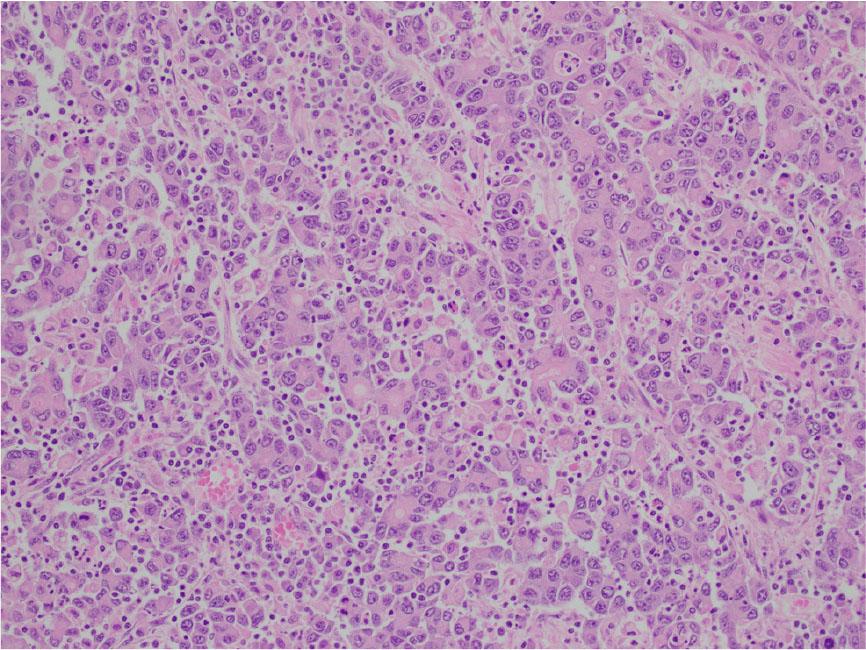
Higher magnification reveals poorly differentiated cells with medium to large-sized vesicular nuclei, nucleoli, and moderate eosinophilic cytoplasm. The larger carcinomatous cells are interspersed by the smaller tumor infiltrating lymphocytes.

Figure 1:

Figure 2:

Figure 3:

© 2025 Lakshmi Manogna Chintalacheruvu, Vamsi Krishna Chilluru, Narendra Babu Gutta, Heather Barrett, published by Helenic Society of Medical Oncology
This work is licensed under the Creative Commons Attribution-NonCommercial-NoDerivatives 4.0 License.